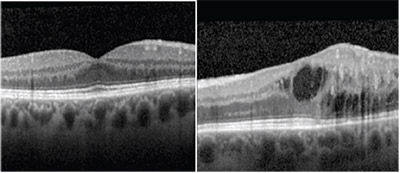

![]() |
| Figure 1. Fundus photographs show a few drusen in the nasal macula in the right eye and multiple dot blot hemorrhages with associated exudates and retinal edema in the temporal macula of the left eye. |
Best-corrected visual acuity was 20/20 and 20/30 in the right and left eyes, respectively. Intraocular pressure was 10 mmHg in both eyes. Pupils were equal and symmetrically reactive without afferent pupillary defect. Extraocular motility and confrontational visual fields were full in each eye. Anterior segment exam was only notable for 1+ nuclear sclerotic cataracts in each eye.
Dilated fundus exam was unremarkable in the right eye apart from a few drusen in the nasal macula and inferior cobblestone degeneration. In the left eye, the dilated fundus exam demonstrated multiple dot blot hemorrhages with associated exudates and retinal edema in the temporal macula (Figure 1). Temporal and inferior lattice degeneration was visible in the periphery, as was a posterior vitreous detachment with a Weiss ring.
We noted some vascular dilatation in the left temporal macula, but no vascular tortuosity, cotton wool spots or peripheral hemorrhages in either eye.
![]() |
| Figure 2. Optical coherence tomography shows normal foveal contour and retinal architecture in the right eye and retinal edema with intraretinal fluid and attenuation of the ellipsoid zone temporally in the left eye. |
Optical coherence tomography showed normal foveal contour and retinal architecture in the right eye. OCT in the left eye showed loss of the foveal contour, intraretinal fluid centrally and temporally, attenuation of the ellipsoid zone temporally and dilated vascular walls (Figure 2).
Fluorescein angiography with transit of the left eye showed normal transit time and vascular filling, but demonstrated dilated, telangiectatic and aneurismal vessels temporal to the foveal center. Slow petalloid leakage around and temporal to the fovea in late frames was also noted. FA of the right eye showed a normal filling pattern without leakage or vascular abnormalities (Figure 3).
Diagnosis and Management
This patient had a mild reduction in visual acuity and visual distortion in the left eye with findings of unilateral retinal hemorrhages, telangiectasia, edema and aneurismal vascular dilatation in the temporalmacula. The differential diagnosis in this case of unilateral macular vasculopathy with telangiectasias and retinal edema should include retinal vein occlusion, diabetic retinopathy, radiation retinopathy, Eales’ disease, idiopathic macular telangiectasia, Coats’ disease and carotid artery obstruction.
This patient has no history of diabetes or radiation exposure. The normal transit time of the FA is not consistent with a diagnosis of ocular ischemic syndrome from carotid artery obstruction. The normal filling on FA without vascular tortuosity is not suggestive of retinal vein occlusion. Both Eales’ and Coats’ disease are characterized by unilateral aneurysmal telangiectasias with exudation, but the pathology is generally more widespread throughout the fundus and periphery in these cases. In contrast, the retinopathy in our case is confined to the parafoveal region, which led us to the diagnosis of Type 1 idiopathic macular telangiectasia.
We offered treatment for the macular edema with exudates, central IRF on OCT and active petalloid leakage on FA. Options reviewed included anti-VEGF therapy as well as laser photocoagulation. The patient elected for observation given his longstanding, stable and relatively mild symptoms, but he will consider treatment in the future.
![]() |
| Figure 3. Fluorescein angiography with transit of the left eye shows dilated, telangiectatic and aneurismal vessels temporal to the foveal center with slow petalloid leakage around and temporal to the fovea in late frames. |
Idiopathic macular telangiectasia (IMT), also known as idiopathic parafoveal, perifoveal or juxtafoveal retinal telangiectasia, is a descriptive term used for a group of conditions characterized by exudation from ectatic and incompetent retinal capillaries in the juxtafoveal region.
This contrasts with conditions of generalized retinal telangiectasias, such as in Coats’ disease, and with secondary retinal vascular abnormalities, such as those seen in vein occlusions, diabetes and carotid artery insufficiency. As the name suggests, the etiology of IMT is unknown.1
The condition was first classified in three broad groups by J. Donald Gass, MD, and Ray T. Oyakawa, MD, in 1982.2 Group 1 IMT is characterized by unilateral parafoveal telangiectasias in the temporal macula, and is often accompanied by lipid-rich exudation.
This is our patient’s diagnosis, which we will mainly focus on.
Type 2 IMT is characterized by acquired bilateral telangiectasias, right-angled vessels, foveal atrophy, superficial crystals and, in some cases, choroidal neovascular membranes. Type 3 IMT, the rarest form, is characterized by progressive occlusion of the perifoveal capillary network.1-3
Idiopathic Macular Telangiectasia Type 1
Although IMT type 1 is considered congenital, it is nonfamilial. Males are most commonly affected and symptom onset usually occurs by age 35 years. FA typically shows prompt retinal vasculature filling and demonstrates the telangiectatic vessels of both the superficial and deep capillary networks in the temporal macula.
Because up to one-third of cases may have focal extramacular telangiectasias, many consider IMT to be within the spectrum of Coats’ disease. Unlike Type 2 IMT, pigment proliferation and neovascularization is not characteristic of Type 1 IMT. Visual acuity is usually mildly affected, ranging from 20/25 to 20/40, with chronic cystoid macular edema as the most common cause of vision loss.1-3
Treatment of Type 1 IMT focuses on the management of CME. The mainstay of treatment has historically been photocoagulation, as Dr. Gass described.2,4 Small (100 μm) burns of moderate intensity applied in a grid pattern to the temporal macula while avoiding the capillary-free zone have been found to be successful in reducing exudation and improving visual acuity.2
Intravitreal injection of triamcinolone acetonide has also been shown in case reports to reduce the volume of macular edema, but the effect was short-lived and visual acuity results were variable.5
More recently, intravitreal injection of anti-VEGF agents has been investigated. Early promising reports on the use of bevacizumab (Avastin, Roche/Genentech) demonstrated significant and sustained decrease in macular edema. However, others found that some Type 1 IMT patients may become refractory to bevacizumab and ranibizumab (Lucentis, Roche/Genentech).6
In one such case of a patient refractory to both intravitreal bevacizumab and laser photocoagulation, intravitreal aflibercept injection significantly improved both macular edema and visual acuity.7
Type 1 IMT is an uncommon condition characterized by unilateral telangiectasias in the temporal macula with exudation and macular edema contributing to mild degrees of visual impairment. The CME component of this disease can be managed with a combination of laser and anti-VEGF therapy, and the prognosis is favorable.
References
1. Agarwal A. Gass’ Atlas of Macular Diseases. 5th ed., Vol. 1. Philadelphia: Saunders;: 522-526.
2. Gass JD, Oyakawa RT. Idiopathic juxtafoveolar retinal telangiectasis. Arch Ophthalmol. 1982;100:769–780.
3. Yannuzzi LA, Bardal AM, Freund KB, et al. Idiopathic macular telangiectasia. Arch Ophthalmol. 2006;124:450–460
4. Nowilaty SR, Al-Shamsi HN, Al-Khars W. Idiopathic juxtafoveal retinal telangiectasias: A current review. Middle East Afr J Ophthalmol. 2010; 17:224-241.
5. Li KK, Goh TY, Parsons H, Chan WM, Lam DS. Use of intravitreal triamcinolone acetonide injection in unilateral idiopathic juxtafoveal telangiectasias. Clin Exp Ophthalmol. 2005;33:542-544.
6. Gamulescu MA, Aalter A, Sachs H, Helbig H. Bevacizumab in the treatment of idiopathic macular telangiectasia. Graefes Arch Clin Exp Ophthalmol. 2008;246:1189-1193.
7. Shibeeb O, Vaze A, Gilles M, Gray T. Macular edema in idiopathic macular telangiectasia Type 1 responsive to aflibercept but not bevacizumab. Case Rep Ophthalmol Med. 2014; 2014:219792.
Dr. Olmos de Koo is an associate professor of ophthalmology and director of the retina fellowship program at the University of Washington in Seattle, where Dr. Tyring is a first-year fellow in vitreoretinal surgery.